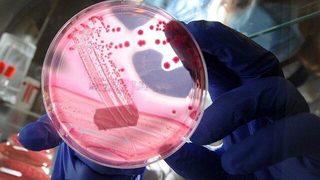
Kanser korkusu tedaviyi bıraktırıyor

Erken Menopoz Haberleri Ve Son Dakika Erken Menopoz Haberleri
Erken menopoz haberleri sayfasında, bu önemli sağlık konusu ile ilgili en güncel gelişmeleri bulabilirsiniz. Dünyada pek çok kadını etkileme potansiyeline sahip olan erken menopoz, kadınların yaşam kalitesini doğrudan etkileyebilir. Bu sayfada, son dakika erken menopoz haberleri ve bu konuyla alakalı bilimsel araştırmalar üzerinden hazırlanan güncel erken menopoz haberlerine erişebilirsiniz.
Erken menopoz ile ilgili son dakika haberleri, bu durumun belirtileri, tedavi yöntemleri ve yaşam tarzı değişiklikleri hakkında bilgilendirici içerikler sunarak, okuyucuların bilinçlenmesine katkıda bulunmayı hedefliyoruz. Günlük yaşamda karşılaşılan zorluklar ve çözümleri üzerine bilgiler, okuyucularımıza yardımcı olması açısından büyük bir önem taşımaktadır. Sonuç olarak, bu sayfa, erken menopoz hakkında kapsamlı ve faydalı içerik sağlamak için tasarlanmıştır.

Haber Gönder
Haber Gönder